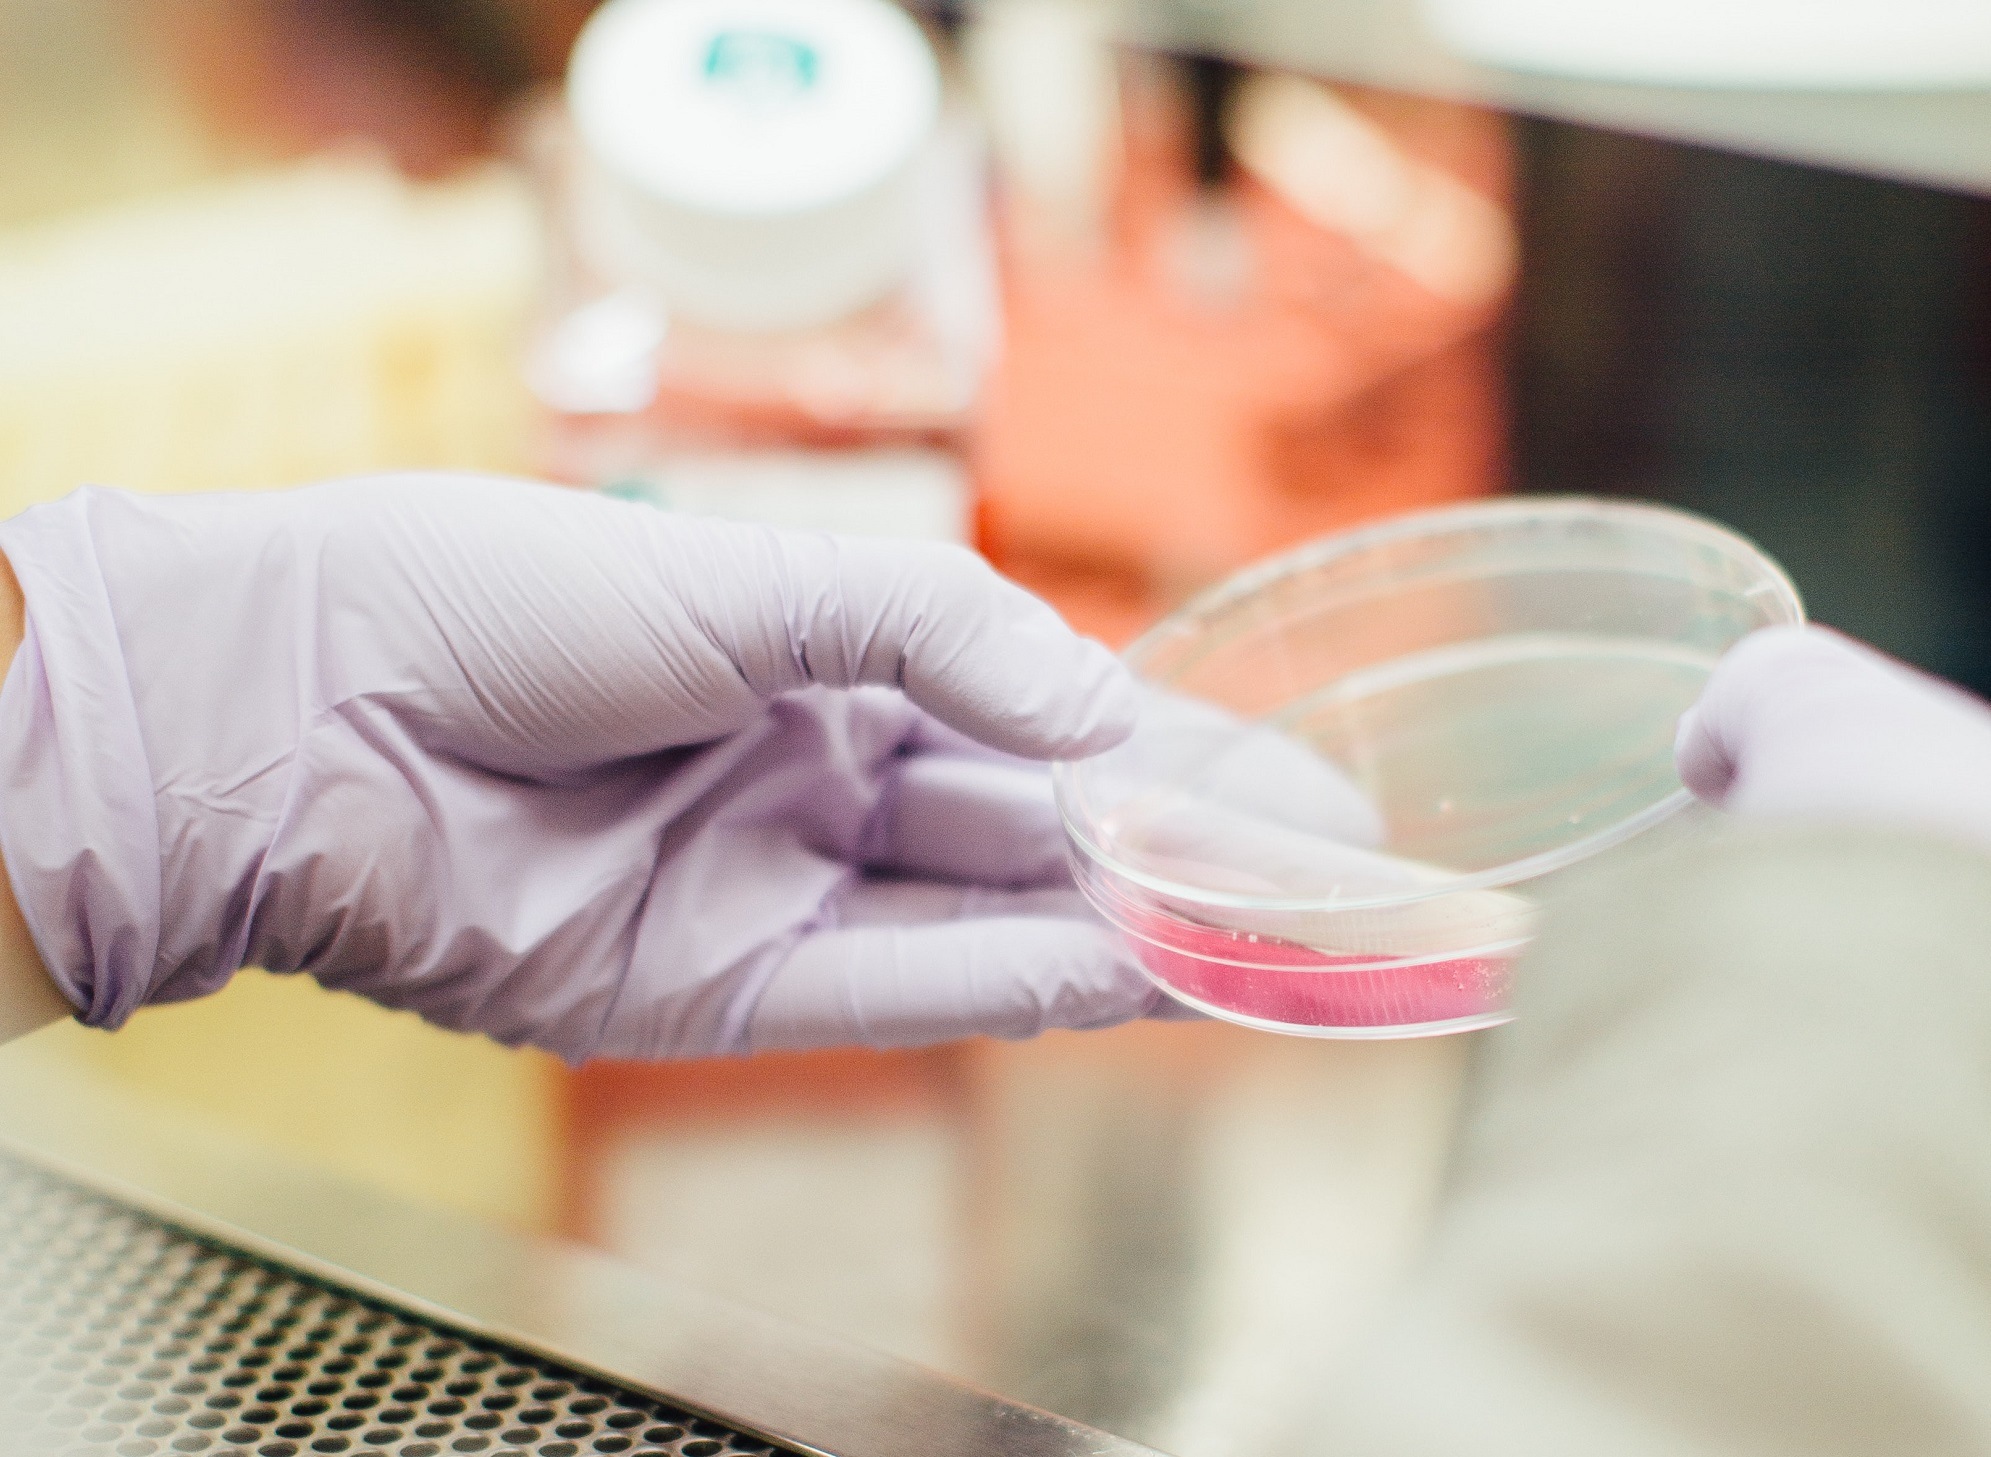

Obrovský krok pre ľudstvo: Už o 5 rokov budeme jesť mäso vypestované v laboratóriu
- Môže slúžiť ako náhrada mletého hovädzieho mäsa v hamburgeroch
- Bunkové mäsové výrobky sa môžu v supermarketoch začať objavovať v priebehu nasledujúcich piatich rokov
Vieš si predstaviť, že si v reštaurácii objednáš steak z „bunkového“ mäsa alebo si z neho doma pripravíš fašírky? O päť rokov sa to s najväčšou pravdepodobnosťou stane realitou. V súčasnosti prebiehajú výskumy s cieľom zistiť, čo si o laboratórnom mäse myslia spotrebitelia.
Obmedzenie mäsa je podľa mnohých vedcov jedným z najlepších spôsobov, ako pomôcť k záchrane našej planéty. Aj preto sa hľadajú alternatívy k pôvodným živočíšnym produktom. Informuje o tom portál Unilad s odvolaním sa na štúdiu, ktorú vykonáva University of Guelph v Kanade.
Otázke klimatickej krízy sa venuje aj Bill Gates. Vo svojej novej knihe s názvom Ako sa vyhnúť klimatickej katastrofe vidí riešenie práve vo vývoji kultivovaného mäsa. Apeluje na vyspelé a bohaté štáty, aby jeho výskumu venovali zaslúženú pozornosť.
Identické mäso
Supermarkety dnes ponúkajú rôzne vegetariánske a vegánske pokrmy. Mäso vypestované v laboratóriu ešte nie.
Simon Somogyi, riaditeľ Longo’s Food Retail Laboratory a predseda Arrell v odbore potravín na University of Guelph v Kanade vysvetlil, že tvorba bunkového mäsa zahŕňa kmeňové bunky zo zvieraťa, ktoré je možné „pestovať“ vo fermentačnej nádobe, ktorá potom kvasí a vytvára mäso.
„Produktom tohto procesu je tak mäso, ktoré je identické s tým, ktoré pochádza zo zvieraťa,“ povedal Somogyi pre portál Sudbury.
Vyjadril takisto presvedčenie, že bunkové mäsové výrobky sa môžu v supermarketoch začať objavovať v priebehu nasledujúcich piatich rokov.
V snahe zistiť, či by si zákazníci reálne kupovali laboratórne vypestované mäso, sa kanadská univerzita v Guelphe spojila s bunkovými poľnohospodárskymi spoločnosťami Second Harvest a Cellular Agriculture Canada, pričom sa okrem iného zaoberajú aj touto otázkou.

„Je tu trochu neistoty aj váhavosti. Je to niečo nové a nezvyčajné,“ povedal Simon Somogyi. Portál Unilad ďalej informuje, že táto technológia je stále v počiatočných fázach.
Pripustil aj to, že laboratórne vypestované mäso pravdepodobne nebude konkurovať zvieraciemu mäsu asi nasledujúcich 25 rokov. Muselo by sa vyrábať za cenu, ktorá je konkurencieschopná. Očakáva sa však vyššia cena a menší výber „mäsových“ produktov.
Nová a neznáma technológia
Podľa portálu Sudbury má laboratórne mäso veľký potenciál. Priemysel vypestovaného mäsa sa rýchlo presadzuje po celom svete. Prieskum trhu spoločnosti Technavio uvádza, že globálny trh s týmto mäsom má potenciál v nasledujúcich troch rokoch vzrásť o viac ako 200 miliónov amerických dolárov.
Faktom však je, že táto technológia je nová a málo sa vie o tom, či sú ľudia ochotní jesť mäso pestované v laboratóriu alebo nie.
Somogyi povedal, že v priebehu nasledujúcich piatich rokov môžu existovať bunkové mäsové výrobky, ktoré môžu slúžiť ako náhrada mletého hovädzieho mäsa a nahradia tak klasické mäso v hamburgeroch.
Pred 8 rokmi, v roku 2013, predstavil holandský výskumník Mark Post hamburgerový produkt, ktorý vyrobil v laboratóriu z hovädzích kmeňových buniek. Odhaduje sa, že tento prvý syntetický mäsový výrobok stál 375 000 amerických dolárov a bol predstavený ako prvé laboratórne vypestované mäso na svete.
Somogyi pre Sudbury uviedol, že táto technológia odvtedy pokročila a niektorí vedci sa domnievajú, že v nasledujúcich 10 až 15 rokoch bude možné nielen vyrábať mäso, ale aj ďalšie produkty v poľnohospodárskom priemysle, a to vrátane rýb.
Dodal, že ak sa svet dostane do bodu, keď bude mäso pestované v laboratóriách identické s tým bežným, bude to problém pre mäsový priemysel.
Náhrada hospodárskych zvierat
Nedávno sme informovali, že český startup Bene Meat Technologies (BMT) ako prvý v strednej a východnej Európe vyvíja technológiu produkcie kultivovaného mäsa. To vzniká kontrolovaným množením živočíšnych buniek.
V laboratóriu vypestované mäso nie je hocijakou náhradou či alternatívou, ako napríklad populárny Beyond Meat. BMT nechce vo výskume kompromisy, ako je napríklad miešanie buniek s rastlinnými proteínmi. Má v úmysle úplne nahradiť „hospodárske zvieratá“ na všetkých úrovniach.
Cieľom tímu výskumníkov, na ktorého čele je biológ Jiří Janoušek, je okrem iného aj zastaviť zbytočné zabíjanie zvierat v rozšírených, no nehumánnych veľkochovoch.
„Vyvíjame technológiu na výrobu plnohodnotnej alternatívy mäsa. Prečo nahradiť mäso, keď môžeme nahradiť zvieratá, ktoré sú dnes kvôli mäsu chované v nevyhovujúcich podmienkach a umierajú v strese?“ pýta sa Roman Kříž, ktorý túto technológiu predstaví na konferencii Plant-Powered Perspectives Slovakia v nasledujúcich týždňoch.
Čítaj viac z kategórie: Zaujímavosti
Zdroje: Unilad, University of Guelph, Sudbury, Bene Meat Technologies